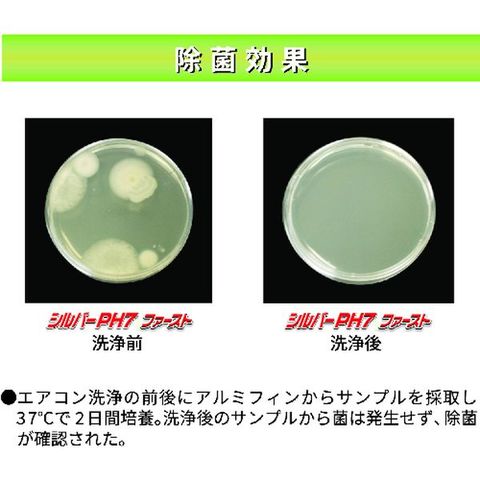

横浜油脂工業(株) Linda シルバーPH7ファースト10kg
販売価格
8,169
円 (税込)
- 出荷目安:
- 1日~2日以内に発送予定(日曜除く)
たまるdポイント(通常) 74
※たまるdポイントはポイント支払を除く商品代金(税抜)の1%です。
dカードでお支払ならポイント3倍
- 商品情報
- レビュー
・アルミフィンを傷めず洗浄後の中和処理が不要です。・生分解性の高い界面活性剤を配合しています。・エアフィルタや熱交換器を洗浄することで、消費電力を20~40%削減できCO2排出量を削減できます。
・アルミフィン・フィルターの洗浄に。
・容量(ml):9900.9・色:無色~淡黄色透明・タイプ:中性・希釈倍率:10倍・縦(mm):235・横(mm):175・容量(kg):10・容量(g):10000・容量(L):9.9
・中性タイプ
・主成分:非イオン系界面活性剤、キレート剤、除菌剤、銀イオン
・生産国 日本
・JANコード 4979782049155
・質量 10kg
・コード:208-3433 ・品目:NB57
・アルミフィン・フィルターの洗浄に。
・容量(ml):9900.9・色:無色~淡黄色透明・タイプ:中性・希釈倍率:10倍・縦(mm):235・横(mm):175・容量(kg):10・容量(g):10000・容量(L):9.9
・中性タイプ
・主成分:非イオン系界面活性剤、キレート剤、除菌剤、銀イオン
・生産国 日本
・JANコード 4979782049155
・質量 10kg
・コード:208-3433 ・品目:NB57